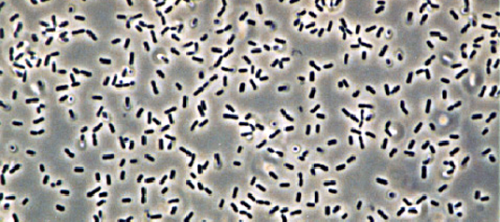
High-Pressure NMR Reveals Dynamic Structure of Proteins

A pressure of 3,000 bar is applied to the cold shock protein B of Bacillus subtilis in a small tube in the NMR spectroscopy laboratory at the University of Konstanz. This is roughly three times the water pressure at the deepest point of the ocean. The pressure is so intense that the highly dynamic protein shows structural features that would not be sufficiently visible under normal pressure.
But why do scientists apply such high pressure, which does not occur anywhere else on our planet under natural conditions? The answer is: To study processes and properties that are too volatile to be observed under normal conditions.
"This high pressure allows us to make states visible that actually do exist at 1 bar, but which we can only observe directly at 3,000 bar," explains Frederic Berner, University of Konstanz. Literally "under high pressure," the doctoral researcher investigates the properties of a protein determined by its structure, and how changes in the structure in turn influence its properties.
In the research group Physical Chemistry and Nuclear Magnetic Resonance at the University of Konstanz, led by Michael Kovermann, he recently implemented a new method for analyzing the structural properties of proteins at 3,000 bar with as little influence as possible from surrounding effects.
The two researchers now present their new methodological approach in the journal Angewandte Chemie International Edition.
Proteins are the basic building blocks of life. They consist of amino acid chains whose three-dimensional structure can take on a wide variety of formations. They "fold" in the same way as a long paper ribbon can be folded into different shapes.
The functional properties of a protein depend largely on its folding, so that the same protein can have very different effects in the cell, depending on the form in which it is folded. "What is important for proteins is their structure, which in turn is linked to functionalities. If you want to identify biochemical mechanisms, you need information about their structure," says Berner.
Scientists aim to capture the properties of the protein structure in its "pure" form—as unclouded as possible by influences from its environment. For two reasons, however, that is not so easy: First, there are almost always interactions with the solvent surrounding the protein and with neighboring sections of its molecular chain.
Second, proteins are highly dynamic, their folding is always in motion. For example, there are proteins that constantly fold apart and go back like scissors. In the fraction of the second it opens, a chemical reaction takes place. This happens far too quickly for researchers to be able to examine it directly.
And this is where the pressure of 3,000 bar comes in: The molecule is pressed into a certain state—its structure is manipulated: The scissors remain open. Using magnetic resonance spectroscopy, the researchers can now study specific structural properties of the protein that are not directly visible under normal pressure.
Previous analysis methods often have accepted the environmental effects and try to factor them out afterward. Kovermann's and Berner's new high-pressure method, in contrast, can suppress or "correct" the environmental effects from the outset ("intrinsically") and thus allows a view of the protein that is affected as little as possible. It makes particular sense to use and compare the new method in combination with existing methods, as this way the various influencing factors become visible in detail.
The high-pressure process invented at the University of Konstanz has brought about very good results even in the early phase of its application. Berner and Kovermann explain that further experiments and computer simulations will now take place to further test and potentially refine the process.
More information: Frederic Berner et al, Including the Ensemble of Unstructured Conformations in the Analysis of Protein's Native State by High‐Pressure NMR Spectroscopy, Angewandte Chemie International Edition (2024). DOI: 10.1002/anie.202401343
Journal information: Angewandte Chemie International Edition
Provided by University of Konstanz